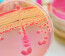

主页内容
新闻
今天支持帝国的一份礼物
礼物帝国可以提供重要的助学金,奖学金和一条生命线在财政困难学生。
今天做一个礼物就读于帝国
明白为什么来自世界各地的学生选择学习。
研究和创新
REF 2021发现帝国有更大比例的世界领先的研究比其他英国大学
是什么在帝国
事件- - - - - -
会议人工智能(AI)的加速发现- - - - - -
培训课程Celcat生活训练——课堂的基础- - - - - -
研讨会香港理工大学詹姆斯·黄:稍后通知- - - - - -
培训课程介绍矿业和矿业金融在线课程